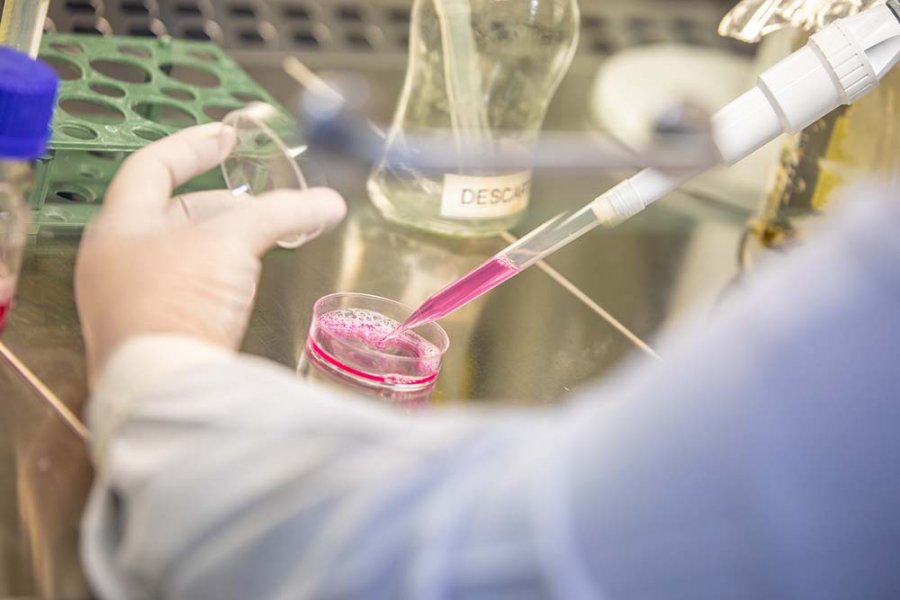

El trabajo se realiza en el Centro de Medicina Comparada de la Facultad de Ciencias Veterinarias de la Universidad Nacional del Litoral que forma parte del ICiVet-Litoral, instituto de doble dependencia UNL-CONICET. El CMC es una plataforma tecnológica única en su tipo en el sistema científico – académico argentino.
La Universidad Nacional del Litoral participa en las pruebas de validación de la Vacuna Sputnik VIDA. Las tareas se llevan a cabo en el Centro de Medicina Comparada (CMC) de la Facultad de Ciencias Veterinarias de la UNL que forma parte del ICiVet-Litoral, instituto de doble dependencia UNL-CONICET.
El CMC es una plataforma tecnológica única en su tipo en el sistema científico – académico argentino. Convocado por el Laboratorio Richmond, este Centro de FCV-UNL está realizando pruebas regulatorias para la vacuna Sputnik V contra el COVID-19 que se produce en el país con la fórmula del Centro Gamaleya. “Es un orgullo tanto para el sistema universitario nacional como para la UNL contar con este Centro tan importante para la salud pública argentina e internacional. El CMC es una apuesta de nuestra Universidad en alianza estratégica con el CONICET que, por sus capacidades, características y certificaciones, es único en su tipo y permite realizar avances claves como el de las pruebas en la vacuna Sputnik V de producción nacional”, aseguró el rector Enrique Mammarella.
CMC y vacunas COVID-19
En este contexto, además, el CMC participa en otro importante desarrollo de vacuna contra el COVID-19. Se trata de una investigación impulsada por la Fundación Instituto Leloir (FIL) y el CONICET cuyos resultados ya indujeron una respuesta inmune muy potente en laboratorio. Ahora, a partir de un acuerdo con la compañía biotecnológica Vaxinz, se busca escalar la producción y desarrollar ensayos clínicos. “Desde el CMC estamos trabajando en el diseño y ejecución de las estrategias de ensayos preclínicos regulatorios para armonizar no solo los requerimientos de ANMAT, sino también de otras agencias regulatorias”, explicó el director del CMC y vicedecano de FCV-UNL, Hugo Ortega.
Luego, Ortega subrayó que “el Centro de Medicina Comparada ha brindado apoyo tecnológico para lograr grandes avances del sector farmacéutico argentino, apoyando a muchos grupos académicos y empresas que tienen interacción con el sector científico, dando soluciones tecnológicas no disponibles previamente en el país. Es una plataforma tecnológica única en su tipo en todo el país ya que cuenta con todas las habilitaciones regulatorias y acreditaciones necesarias para la realización de ensayos preclínicos de alta complejidad”.
Único en el país
“Entre los desarrollos realizados en los últimos años en el CMC se pueden destacar los estudios preclínicos para registro de los primeros anticuerpos monoclonales producidos en la región por la empresa mAbxience. El estudio preclínico integral de patentes generadas por el Dr. G. Rabinovich dentro de la estrategia de CONICET y MINCYT de realizar un desarrollo integral previo a su licenciamiento”, explicó Ortega.
El CMC – ubicado en Esperanza-- participó activamente en el desarrollo integral de los estudios preclínicos para un tratamiento innovador (primer medicamento biológico integralmente desarrollado en el país) para el Síndrome Urémico Hemolítico para la empresa Inmunova SA a partir de patentes pertenecientes al grupo dirigido por el Dr. Fernando Goldbaum. Este último desarrollo sirvió de base para la aprobación de las fases clínicas del suero equino hiperinmune anti-COVID-19, primer tratamiento desarrollado íntegramente en Argentina y fundamental para hacer frente a la pandemia actual.
Luego, el director del CMC y vicedecano de FCV-UNL sostuvo: “En colaboración, participamos en un proyecto importante de vacunas anti-COVID presentado al CEPI (Coalition for Epidemic Preparedness Innovations), junto con el grupo del Dr. Osvaldo Podhajcer del Instituto Leloir y la empresa Vaxinz de Estados Unidos. A su vez, trabajamos, con la Dra. Karina Pasquevich, de la estrategia de ensayos preclínicos para la vacuna desarrollada en la UNSAM. CMC es el único Centro en el país en disponer de un modelo transgénico de ratones que permite la evaluación de terapias específicas para COVID-19. Además, estamos colaborando con la Dra. Leda Castilho, de la Universidad Federal de Rio de Janeiro, Brasil, para realizar los estudios preclínicos de otra vacuna para COVID-19”.
Compromiso científico
“En la actual emergencia, preparamos y ejecutando en menos de 10 días un protocolo para determinar la eficacia del Ciclador Automático para Resucitador (CAR) a pedido de Inbio SA y de las autoridades sanitarias de la Provincia de Santa Fe, para aumentar la cantidad de respiradores disponibles. Dicho equipo fue aprobado por ANMAT basado en parte, en los informes que emitimos”, continuó Ortega para valorar más adelante que “durante esta pandemia brindamos asesoramiento a numerosos grupos de otros institutos argentinos y de países europeos y latinoamericanos sobre aspectos regulatorios y diagramación de ensayos biológicos para nuevos fármacos y dispositivos médicos requeridos en el marco de la pandemia COVID-19. Todo esto es posible gracias a un equipo de trabajo integrado por más de 60 profesionales de diferentes disciplinas, que constituyen la base de todos los desarrollos realizados”.
Premio y acreditaciones
El CMC es la primera entidad estatal en obtener la conformidad con BPL-OCDE constituyéndose así en el único Centro integrado a una institución del Sistema Científico-Tecnológico en el país que conjuga las certificaciones y habilitaciones correspondientes a SENASA, ANMAT, ISO 9001 y BPL-OCDE.
En 2019, el CMC obtuvo el Premio Nacional a la Calidad, otorgado por la Dirección Nacional de Procesos, Calidad y Eficiencia de Gestión, siendo la primera entidad del CONICET y la UNL en lograrlo.
Las acreditaciones que el Centro posee permiten a diferentes grupos de I+D dar el ‘salto’ necesario para llegar a demandantes exigentes que requieren la validación de los hallazgos científicos antes de adoptarlos o transferidos. En particular, el CMC brinda soporte tecnológico y contribuye a la realización de ensayos para más de 50 grupos de investigación, de 11 provincias y del exterior (Brasil, Chile, Uruguay, España, etc.).
Desde el CMC, UNL y CONICET han transferido conocimiento y tecnologías para avances de la biomedicina argentina, apoyando a muchos grupos que tienen interacción con el sector productivo, dando soluciones no disponibles previamente en el país. Se logró conjugar en un solo centro capacidades que le han permitido a muchos grupos de investigación, disponer de una plataforma tecnológica de investigación y desarrollo no existente previamente en el país, constituyendo una importante innovación tecnológica para el sector científico. Se brindó al país y la región la posibilidad de disponer de una plataforma única, aplicando conocimientos científicos básicos a la investigación preclínica, y a su vez, permitiendo el intercambio entre investigadores básicos, preclínicos y clínicos, y con laboratorios de apoyo que cumplan con altos estándares de calidad.